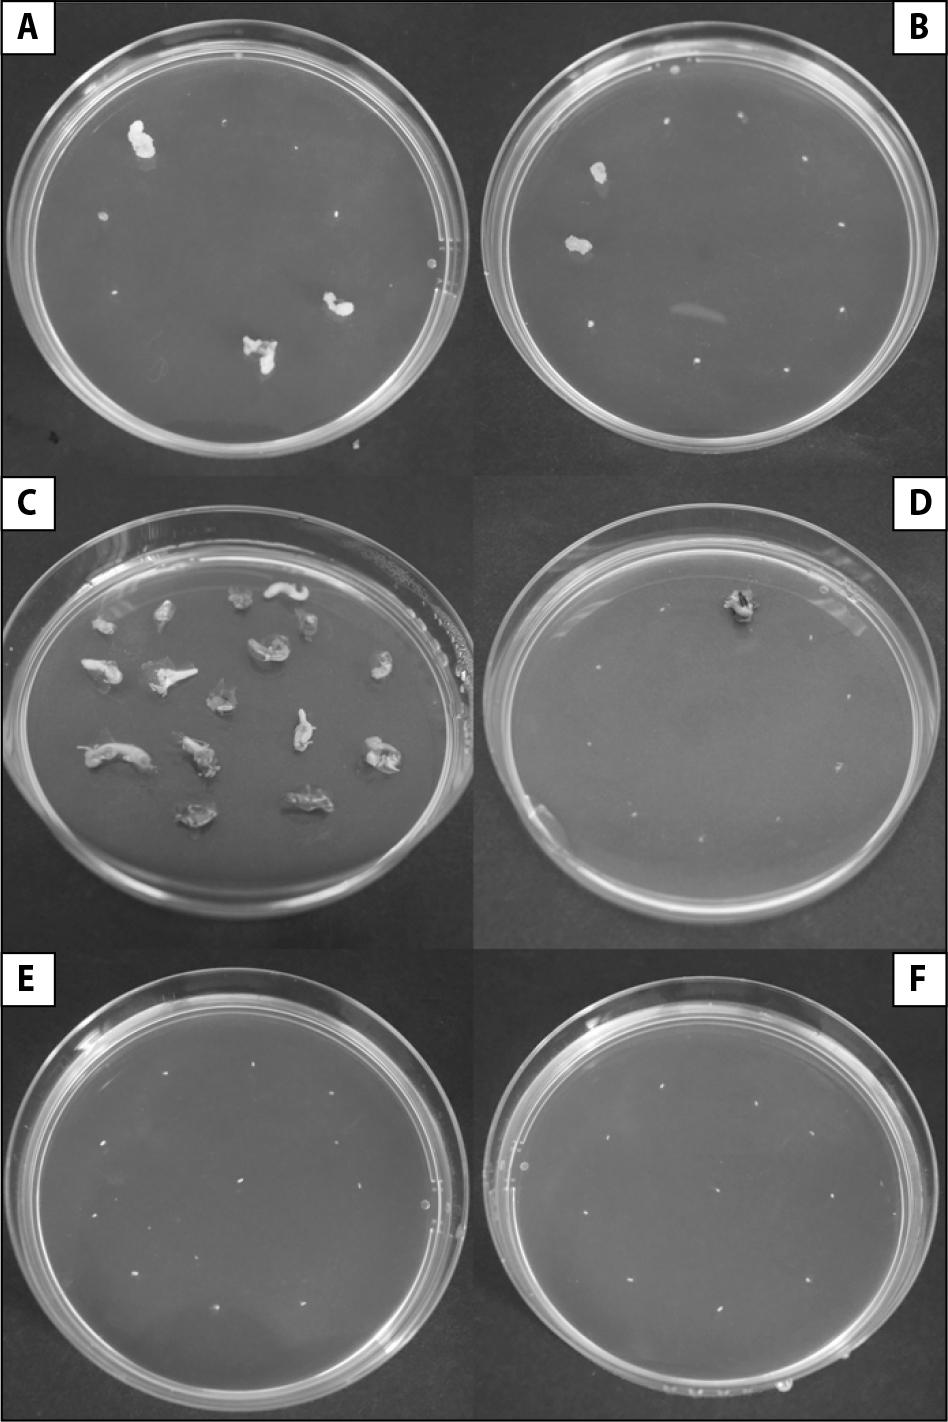
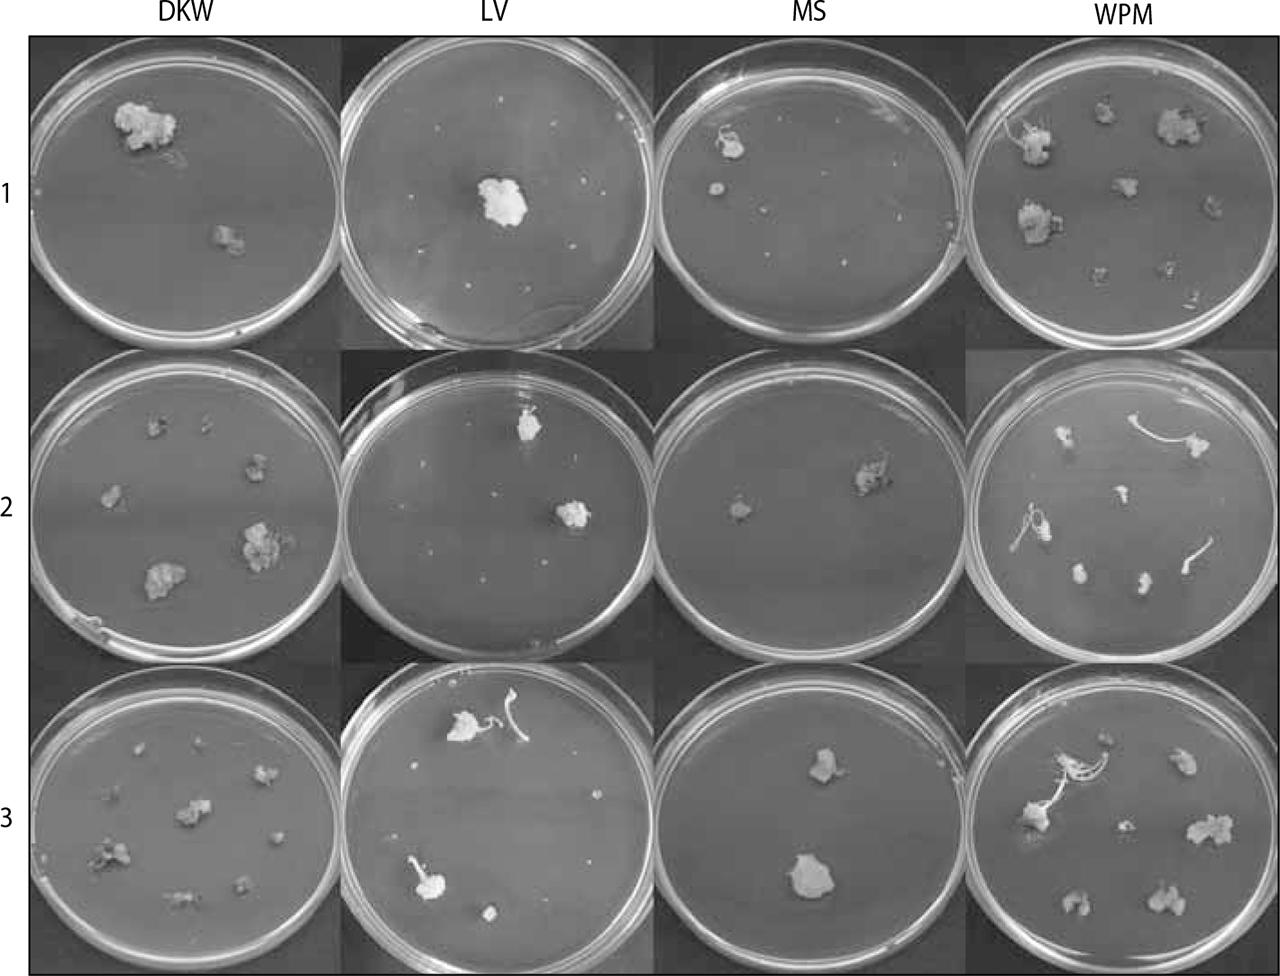
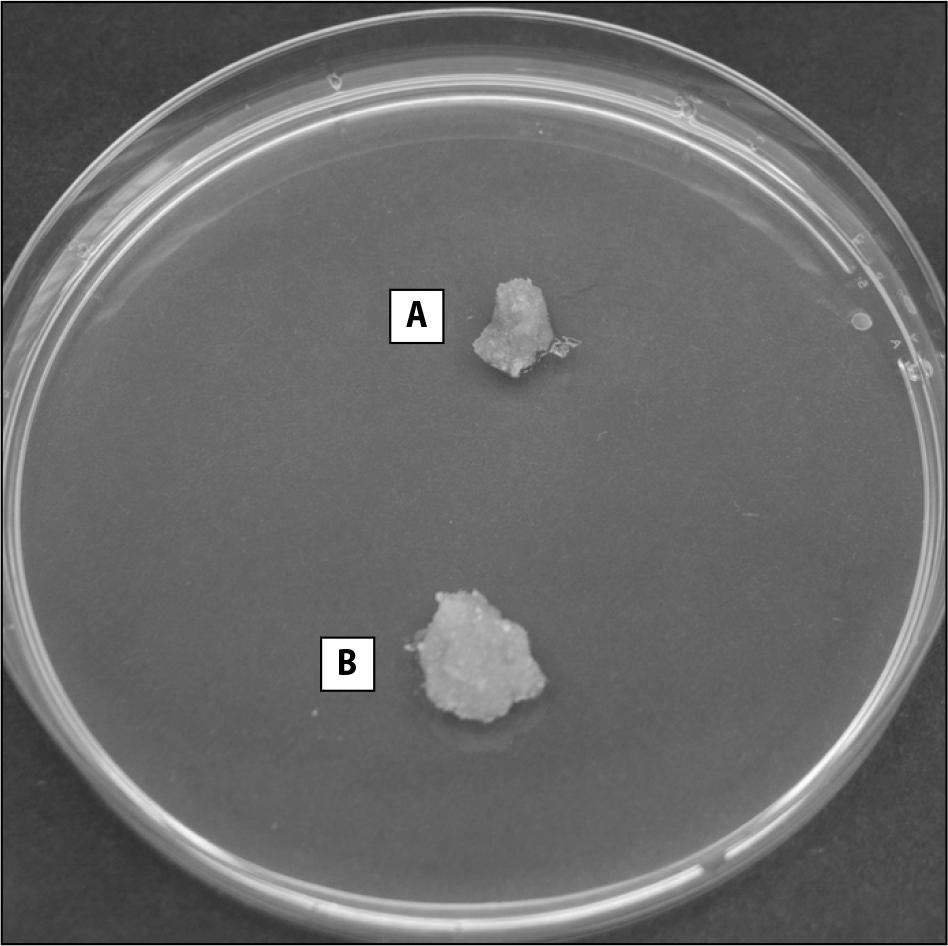

Trees provide a habitat for a variety of organisms, ranging from microscopic fungi to insects and animals. However, the most relevant aspect from the perspective of urban forest ecosystem conservation and biotechnology is the prevention of infection by various fungal pathogens. The primary method is the development of repellents or plant varieties that are resistant to phytopathogenic fungi (Peng et al. 2021). Fungal pathogens exert high pressure on host plants, causing them to activate a number of defence mechanisms. In response, fungi attempt to combat these barriers (Priyashantha et al. 2023).
Research on fungal pathogens utilises methods derived from biotechnology. Pathogenicity can be assessed using dual cultures, in which two types of tissues are used. The first is the plant tissue (such as callus, a part of the plant or the whole plant) and the second, in this case, the fungal component. This method allows to isolate the resistant plant genotypes and assess the risk of infection under the tested conditions. Plant tissues selected for resistance can be propagated and used as a material for further regeneration by direct organogenesis (Bull and Michelmore 2022). Through breeding in this way, plants can be ensured to be free of infectious diseases and with potentially increased resistance in the future.
The European white elm (Ulmus laevis Pall.) is not an economically important species mainly due to its crossing fibres and low wood density. However, it is used for urban woodland because of its resistance to unfavourable soil and climatic conditions. It is also included as one of the species in riparian forests, among others, although over time it may disappear completely from Poland’s forests through the long-term disasters it has suffered. The first was soil drainage, which led to a lowering of the groundwater table (Jaworski 2011). As a result of the disruption of water relations, the mass emergence of the stemborer spreading graphiosis began (Sokołowski 2004). Despite their high resistance to changes in soil conditions, elm trees quickly become weakened, although the European white elm shows the greatest resistance to disease. Consequently, the Dutch elm disease (DED), which threatens elm trees, has a destructive effect on roadside canopies over time without significantly interfering with forest and urban ecosystems. DED causes chronic or acute tree dieback. Of interest is the symbiosis between conidia of the fungus and Scolytus scolytus or S. multistriatus, through which its area of influence increases (Jürisoo et al. 2021). One method to counteract it is the introduction of resistant cultivars (Santini and Faccoli 2015; Napierała-Filipiak et al. 2019). Regeneration of elm trees by in vitro methods is thus becoming an integral way to breed DED-resistant individuals.
In vitro cultures have many practical applications. Plant tissue cultures are an essential tool to producing active compounds, secondary metabolites and food. Their advantage is not only the ability to obtain more substances in a small amount of time but also in ensuring their chemical stability (Nawrot-Chorabik et al. 2024). Chemical compounds are under constant control for their properties, which depend on their structural composition (Espinosa-Leal et al. 2018). For the study of secondary metabolites, most parts of the tree are used: seeds, buds, fruit or roots, among others (Nawrot-Chorabik et al. 2022a). However, these same parts must be properly prepared and studied before experiments can be performed on them. One of the tissues on which experiments can be conducted is the callus obtained in in vitro cultures. Callus is a primate tissue that is readily used for biotechnological research (Nawrot-Chorabik 2015, Nawrot-Chorabik et al. 2024).
To date, no callus has been obtained from embryos derived from immature seeds. Most of the tissues obtained were derived from buds or leaves. Tissues developing on buds mainly differentiated by indirect organogenesis to form callus at the base of the seedling (Aoun et al. 2009; Shukla et al. 2012; Välimäki et al. 2021). On leaves, the development of embryogenic callus producing by somatic embryogenesis was predominant (Conde et al. 2004).
The aim of this study is to develop reliable methods for obtaining callus and seedling tissues of Ulmus laevis under the potentially high threat of DED expansion in Poland. Methods were proposed to obtain plant tissues: callus and seedlings, with the aim of later selecting tissues resistant to external conditions. This will allow future selection of genotypes resistant to fungal factors. The effect of light access and lack of light on callus was also investigated. Our goal was to obtain such tissues so that dual cultures with callus and seedlings in good health could be established in subsequent studies.
This study is based on similar elements as in the work published by K. Nawrot-Chorabik (Nawrot-Chorabik et al. 2024) due to the long-standing collaboration and the subject matter of the PhD thesis of N. Gumulak-Wołoszyn under the supervision of K. Nawrot-Chorabik.
For micropropagation, zygotic immature seed embryos from three approximately 40-year-old Ulmus laevis Pall. trees were used. The origin of the elm trees is shown in Table 1. The seeds were stored at a temperature of about 2°C in a dedicated fridge.
Species and origin of the plant material
| No. | Species | Location and date of seed collection | Forest district | Geographical coordinates |
|---|---|---|---|---|
| 1 | Ulmus laevis | Kraków (Poland) 05.2022 | Krzeszowice |
|
| 2 | Bochnia (Poland) 05.2022 | Brzesko |
| |
| 3 | Wisła (Poland) 06.2022 | Wisła |
|
Development of seed preparation and disinfection of European white elm seeds with isolation of zygotic embryos on unmodified medium with addition of cytokinin
The disinfection was based on micropropagation studies of elm species by Malá et al. (2007) and Välimäki et al. (2021) and ash by Nawrot-Chorabik et al. (2022b, 2024). At the beginning, 2400 live seeds were stripped of their seed coats and sterilised in 70% ethanol for 30 seconds. After this, they were rinsed with distilled water containing a drop of Tween 80 and placed in a beaker with a 5% polyvinyl pyrrolidone (PVP) solution for 24 hours at about 4°C. After this time, the seeds were shaken in 70% ethanol (0.5 min) and rinsed again three times in deionised water.
The seed disinfestation experiment was conducted in 16 different combinations in triplicate on one drawn origin from the three origins held, so as not to suggest later results. Each combination was represented by 50 zygotic embryos. It was tested whether the action of ultrasound prior to disinfection of the seeds proper would improve the disinfection effect, whether it would enhance tissue proliferation or not affect subsequent development. Two compounds commonly used to disinfect the plant material were also tested: sodium hypochlorite (NaOCl) and hydrogen peroxide (H2O2) at a concentration of 8% or 12% and an action time of 7 or 15 minutes to show differences.
The shelled seeds were disinfected in 70% ethanol (0.5 min) and then rinsed under running water (10 min). After this, they were transferred to a beaker with a 5% PVP solution for 24 hours. Once the time had elapsed, the seeds were transferred to a clean beaker and rinsed in ethanol (0.5 min). Depending on the combination, ultrasound (42 kHz) was used at this stage using an ultrasound generator (CHEMLAND, Stargard Szczeciński, Poland), which treated the seeds for 10 minutes, after which time they were transferred to a beaker. The seeds were washed several times with sterile water and transferred to a sterile beaker. Depending on the combination, the beaker was supplemented with the appropriate concentration of H2O2 or NaOCl and the seeds were disinfected for 7 or 15 minutes, respectively (Table 2). The seeds were then washed several times with sterile water to rinse off the disinfectant and transferred to a sterile filter paper. After isolation, embryos were lined onto petri dishes containing WPM culture medium (Lloyd and McCown 1980; Välimäki et al. 2021) without any growth regulators. Assumed combinations are presented in Table 2.
Methods used to decontaminate Ulmus laevis seeds
| Combination | The use of ultrasounds [45kHz] | Disinfectant used | Disinfectant concentration [%] | Disinfection time [min.] |
|---|---|---|---|---|
| 1 | + | NaOCl | 8 | 7 |
| 2 | 15 | |||
| 3 | 12 | 7 | ||
| 4 | 15 | |||
| 5 | H2O2 | 8 | 7 | |
| 6 | 15 | |||
| 7 | 12 | 7 | ||
| 8 | 15 | |||
| 9 | − | NaOCl | 8 | 7 |
| 10 | 15 | |||
| 11 | 12 | 7 | ||
| 12 | 15 | |||
| 13 | H2O2 | 8 | 7 | |
| 14 | 15 | |||
| 15 | 12 | 7 | ||
| 16 | 15 |
Adaptation of a suitable culture medium for Ulmus laevis explants
Four types of media were used in the study: DKW (Driver and Kuniyuki 1984), modified MS (Murashige and Skoog 1962; Patent No: P.433288), LV (Litvay et al. 1985) and WPM. The MS, DKW and LV media selected for this experiment are commonly used for culture in our laboratory. The medium WPM was considered based on the publication of Välimäki et al. (2021). Each medium was supplemented with the same growth regulator 6-benzylaminopurine (BA) at 4.440 μM/l. Growth regulators were prepared at a concentration of 1 mg substance per 1 ml solvent. A total of 600 seeds were disinfected, and embryos were isolated onto the specified culture media at 100 per combination. Three replicates were performed. Cultures were stored in a phytotron at 25°C, 40% humidity and a photoperiod of 16 hours light and 8 hours dark with a warm white light intensity of 60 μmol m−2 s−1 (Nawrot-Chorabik 2024). The culture was carried out for 21 days. During this time, tissues were passaged onto a suitable sterile medium as required.
The experiment used 20 embryos per combination in three replicates (2880 seeds in total) and selected: 6-benzylaminopurine (BA), kinetin (KIN), thidiazuron (TDZ) and gibberellin A (GA3) in various combinations. Growth hormones were tested in the following combinations: BA and KIN, BA and TDZ, BA and GA3, at well-defined concentrations (Result section) followed by determination of which combination formed callus and which combination formed differentiated tissues containing root or cotyledon. The culture medium was supplemented with 20 g/l sucrose and 7 g/l agar. The plant material was cleaned and subjected to a two-step dis-infection process under sterile conditions. During this process, a half-potency culture medium was prepared. In the laminar chamber, each bottle of sterilised nutrient solution was supplemented with a different combination of growth regulators. BA and KIN, BA and TDZ, and BA and GA3 were added through sterile 0.22 μm PES syringe filters at constant concentrations. After 10 days of culture in the dark, the tissues were transferred to the light of the phytotron for 11 days. After 21 days of culture on Petri dishes, the tissues had fully differentiated, and the combination with the most proliferation of tissues with shoot or leaf elements in good health was selected. Once the tissues had reached a minimum length of 1.5 cm, they were cut in half, removing any callus tissue buds if necessary, and then passaged onto the next medium for seedling micropropagation.
The culture of 60 tissues randomly selected from stage “Adaptation of growth regulators to seedling proliferation or callus development” (3 replicates of 20 tissues each) having a root or stem was conducted in a plant growth chamber (Biogent, Fito, Poland) at 23 ± 1°C and 70% humidity, under white light 380–710 nm, photoperiod 12 hours, on the WPM medium with 20 g/l sucrose and 7 g/l agar with 2.887 µM/l GA3 and 2.220 µM/l BA. During the 21-day culture period, tissues were passaged onto new media with identical composition if necessary. After 28 days, tissues with a minimum of one leaf and root buds were transferred onto rooting media in a tall glass dish (80 mm × 45 mm) with a volume of 226 cm3 covered by a 90 mm diameter glass Petri dish. For rooting, WPM media with naphthaleneacetic acid (NAA) or Indole-3-butyric acid (IBA) were used at a concentration of 5.370 µM/l NAA, 4.920 µM/l IBA, 10.740 µM/l NAA or 9.840 µM/l IBA.
After 14 days, the tissues were transferred to a new medium in a tall dish, but the composition of each medium was significantly altered. The content of macro-nutrients, micronutrients, vitamins, sugar and the respective growth regulator was halved, and the amount of solidifying agent was reduced to 6 g × dm−3. After an additional 14 days, the tissues were redeposited in the high dish containing medium again halved in the chemical content, but without the addition of the growth regulator. The tall pans, covered with a Petri dish, were protected with parafilm and transferred to a germinator outside the phytotron within reach of natural light. The room temperature was maintained at 20 ± 1°C. After 14 days, the tissues were washed in sterile water to remove any residual culture medium. If necessary, callus developing at the roots was removed, yellowing leaves were removed, and roots were shortened to 1 cm in length and placed in a plant growing medium with perlite at a ratio of 3:1. Seedlings were watered with sterile water every 4 days.
A total of 45 calluses obtained from the stage “Adaptation of growth regulators to seedling proliferation or callus development” culture were used, and they were divided into three replicates of 15 tissues each. Tissues so far were cultured for 10 days in the dark and 11 days in phytotron light on the WPM medium supplemented with 4.646 µM/l KIN and 4.440 µM/l BA. Each tissue was weighed, cut in half and repotted onto a new medium. This provided two tissues from one initial tissue that could be compared. One part, containing 45 different calluses, was transferred to the dark in the phytotron, and the other part was still kept in light. After 21 days, the experiment was terminated and the results were recorded.
For analysis, the Wilcoxon rank sum test with continuity correction was used along with the Kruskal–Wallis test to determine the performance of individual tissue culture experiments. Pearson’s correlation coefficient was used to determine average tissue sizes in the presence of growth regulators. The same coefficient along with the Kruskal–Wallis test was used to compare the concentration of growth regulators in rooting seedlings. Paired t-test was used to compare weights of callus tissues grown in the dark. Statistical analyses were performed in RStudio version 2022.07.2 + 576 (library tidyverse). A p<0.05 value was considered significant.
The diversity of decontamination methods proved essential in selecting the optimal procedure for sterilising the plant material.
Decontamination without ultrasound in 8% H2O2 for 15 minutes was selected for further study (Fig. 1, 2). Only in the case of combination No. 14, in addition to the abundance of living tissues, attention was also paid to their health status. The tissues were partially browned but reached sizes above 5 mm in diameter.
Experiment to select a suitable disinfection of Ulmus laevis seeds in purpose to isolate suitable combination. Disinfection without ultrasound in 8% H2O2 for 15 minutes proved to be suitable for disinfection of European white elm seeds. A – combination with 8% H2O2 for 7 minutes without ultrasound; B – combination with 8% H2O2 for 7 minutes with ultrasound; C – combination with 8% H2O2 for 15 minutes without ultrasound; D – combination using 8% H2O2 for 15 minutes with ultrasound; E – combination using NaOCl at 8% or 12% for 7 or 15 minutes with or without ultrasound; F – combination using H2O2 at 12% for 7 or 15 minutes with or without ultrasound.

Pairwise comparisons using Wilcoxon rank sum test with continuity correction conducted on 16 combinations of a disinfested elm plant material. Three replicates of 50 tissues were summarised. Kruskal–Wallis chi-squared = 1648.7, df = 15, p-value < 2.2e-16.
Once the disinfection method had been developed, it was important to select a suitable culture medium for the culture. After selecting combination 14 with disinfection in 8% H2O2 for 15 min (Tab. 2, Combination 14), European white elm seed embryos were plated onto media supplemented with 4.440 µM/l BA: DKW, modified MS, LV and WPM. After 28 days of culture in the phytotron, differences were observed in the number of developed embryos and their condition on media supplemented with cytokinin BA (Fig. 3).

Culture medium adaptation experiment for a single random origin collected from seeds of Ulmus laevis embryos on culture media: DKW (A), mod. MS (B), LV (C) and WPM (D) supplemented in 4.440 µM/l BA. Photographs were taken after 28 days of culture. Disinfection of the plant material included a two-step disinfection with H2O2 disinfectant at a concentration of 8%.
Based on the results, MS with BA was selected for further experiments. On the other substrates, tissues did not show potential for differentiation. Those that developed sparingly on the DKW medium and modified MS died within a week. Tissues that reached a size of 0.7 mm on the WPM medium were considered optimal for further studies because of their growth rate. The dying process then does not occur drastically due to the constant growth or the capacity for organogenesis.
Once the results were obtained, the entire experiment was repeated on all three origins in triplicate. The isolated embryos were subjected to a two-step disinfection with 8% H2O2 for 15 minutes. Thus prepared were plated on DKW media, mod. MS, LV and WPM supplemented with 4.440 µM/l BA. The culture was maintained under sterile conditions in the phytotron and completed after 21 days. Representative dishes were selected for photography (Fig. 4).
Ulmus laevis explants obtained from embryos of trees from Kraków (1), Bochnia (2) and Wisła (3) on DKW, LV, mod. MS and WPM supplemented in 4.440 µM/l BA. Photographs were taken after 28 days of culture. Disinfection of the plant material included a two-step disinfection with the disinfectant H2O2 at a concentration of 8%.
Tissues developing on the media after 28 days of culture showed significant variation in size, abundance (Fig. 5) and health condition.

Pairwise comparisons using Wilcoxon rank sum test with continuity correction. The effect of culture media on tissues was investigated. Four types of culture medium were considered in three replicates. Analysis was carried out on all origins with averaging of values. One hundred embryos were used in each of three replicates. Kruskal–Wallis chi-squared = 28.673, df = 3, p-value = 2.623e-06
Explants from the Wisła Forest District (Tab. 1, Origin No. 3) developing on WPM medium supplemented with 4.440 µM/l BA were distinguished from other combinations. On the DKW substrate, the explants took on a dark beige colour. Green microshoots were also frequent, which were cut off and passaged onto the new medium. This proved to be the optimal medium for origin 2. LV medium and mod. MS did not stimulate the development of Ulmus laevis embryos. On the LV medium, the tissues acquired a hard structure and a light beige colour. Some of the embryos developed by indirect organogenesis. With the modified MS medium, the frequency was similar to that on the LV medium. Callus had a dark beige colour, and microspores and microcarps could be observed on some. However, in both of these cases, all tissues quickly turned brown and consequently died. The last medium tested was WPM, on which tissues multiplied abundantly. Differences in colour and structure were evident between the origins. During the experiment, tissues from origin 3 were the most diverse and grew rapidly. After this, an origin was chosen on which pure callus could be obtained.
By varying the growth regulators, it was possible to match the appropriate combination to obtain callus or seedlings in vitro (Fig. 6, 7, 8), and statistical tests were performed using the Pearson correlation coefficient (Tab. 3).

Ulmus laevis tissues obtained from seed-derived embryos. Combinations of concentrations of two growth regulators kinetin and 6-benzylaminopurine added to 1 litre of medium. The majority of callus was obtained. Tissues grown on the WPM medium supplemented with 4.646 µM/l KIN and 4.440 µM/l BA were the most viable among the others

Ulmus laevis tissues obtained from seed-derived embryos. Combinations of concentrations of two growth regulators gibberellin A and 6-benzylaminopurine added to 1 litre of medium. The majority of calluses were obtained with an educated shoot or shoots. Tissues grown on the WPM medium supplemented with 1.444 µM/l GA3 and 4.440 µM/l BA were selected for further seedling studies

Ulmus laevis tissues obtained from seed-derived embryos. Combinations of concentrations of two growth regulators thidiazuron and 6-benzylaminopurine added to a 1 litre of medium. For the most part, the tissues turned brown or died
P-values of mean tissue sizes at combinations of specific concentrations of growth regulators using Pearson’s correlation coefficient. At a significance level of p = 0.05
| Growth regulator and its concentration | 6-benzylaminopurine | ||||
|---|---|---|---|---|---|
| 2.220 µM/l | 4.440 µM/l | 6.660 µM/l | 8.880 µM/l | ||
| Kinetin | 2.323 µM/l | 0.238100 | 0.213310 | 0.238100 | 0.238100 |
| 4.646 µM/l | 0.213310 | 0.238100 | 0.213310 | 0.238100 | |
| 6.969 µM/l | 0.213310 | 0.213310 | 0.238100 | 0.238100 | |
| 9.292 µM/l | 0.238100 | 0.23810 | 0.213310 | 0.238100 | |
| Gibberellin A | 1.444 µM/l | 0.213300 | 0.238080 | 0.213300 | 0.238080 |
| 2.887 µM/l | 0.213300 | 0.21330 | 0.238080 | 0.213300 | |
| 4.331 µM/l | 0.238080 | 0.21330 | 0.213300 | 0.238080 | |
| 5.774 µM/l | 0.213300 | 0.238080 | 0.213300 | 0.213300 | |
| Thidiazuron | 2.270 µM/l | 0.091578 | 0.406010 | 0.287300 | 0.406010 |
| 4.540 µM/l | 0.287300 | 0.091578 | 0.406010 | 0.406010 | |
| 6.810 µM/l | 0.287300 | 0.28730 | 0.091578 | 0.287300 | |
| 9.080 µM/l | 0.406010 | 0.28730 | 0.287300 | 0.091578 | |
European white elm explants obtained on the WPM medium supplemented with specific growth regulators showed high variation depending on the amount of hormones.
Kinetin has a potentiating effect on the cytokinesis step and thus, in combination with BA, induced the proliferation of callus in most cases. The higher the concentration of kinetin, the more compact the tissue became and, on passage, it easily broke down into smaller, rapidly dying parts. The higher the concentration of BA, which causes the formation of new shoots, the more numerous the tissue developed through the process of intermediate organogenesis. The maximum concentration of both regulators led to the formation of white, spreading callus from which single transparent shoots grew. Flexible and fully viable tissues with a pale beige colour were obtained at concentrations of 4.646 µM/l KIN and 4.440 µM/l BA, indicating that the concentrations of the regulators were correctly selected for the growth of U. laevis tissues.
Gibberellin A, due to its germination-stimulating properties, showed very good results in the development of U. laevis embryos by indirect and direct organogenesis. Low concentrations (1.444 µM/l) of GA3 resulted in the development of tissues with a shoot or leaf, but the higher the concentration, the more tissues developed by direct organogenesis. The additional effect of BA caused tissues to reach a smaller size and die more rapidly as the concentration increased. For the tissues obtained in this experiment, the concentrations most favourable for both growth regulators were 1.444 µM/l GA3 and 4.440 µM/l BA. As a result, the tissues developed with high potential to sizes of more than 1.5 cm in length and had a minimum of 2 root hairs developing from callus.
Thidiazuron is a cytokinin used in the tissue culture for plant regeneration and organogenesis. It showed organogenetic effects on European white elm embryos. At the lowest concentration, it did not strongly affect shoot development in tissues, nor did it promote callus development. Tissues reached approximately 10 mm in length. However, the higher the concentration of TDZ was, the tissues browned considerably. The callus, from which shoots developed, died rapidly. Maximum concentrations of both of these regulators resulted in the dwarfing or dying of part or all of the explants. Each tissue completely died after a period of about 35 days. The resulting explants did not show the expected potential, and development was not directed along one of the in vitro regeneration pathways, so the experiment involving TDZ was discarded.
After 42 days of culture on varying concentrations of media with NAA and IBA and a further 14 days on medium without growth regulators, the tissues showed differences in the number of shoots developing by indirect organogenesis (Tab. 4). On the medium supplemented with IBA, a single shoot developed from each tissue in the root of which callus was observed. The shoot had at least four leaves along the entire shoot (Fig. 9A). On medium supplemented with NAA, a minimum of two shoots were differentiated from the callus developing in the root. Each shoot had a minimum of two leaves, which quickly fell away from the bottom of the shoot. This resulted in more developmental energy being transferred to the top leaves. The shoots were thicker and longer compared to shoots developing on IBA medium, and trichome roots developed in large numbers from the callus (Fig. 9B). Out of a total of 60 tissues developing on the WPM medium with lower concentrations of IBA, 15 survived and 23 with higher concentrations.

Ulmus laevis seedlings developing on rooting WPM media. A single main shoot developed on the IBA-supplemented medium (A) irrespective of concentration, with callus growing at its base. The leaves were small but developed along the entire shoot. On the medium supplemented with NAA (B), a callus grew independently of concentration from which a minimum of two shoots developed. The leaves remained viable from the middle of the shoot, allowing them to reach a larger size at the top
Number of tissues isolated from individual 30 primary seedlings showing multistemming ability. From the initial 15 tissues on WPM medium supplemented with 5.370 µM/l NAA, 35 separate seedlings were obtained at the end. From the initial 15 primary tissues on WPM medium supplemented with 10.740 µM/l NAA, a total of 48 separate tissues were obtained
| Number of tissue | Amount of NAA growth regulator per litre of medium | |
|---|---|---|
| 5.370 µM/l | 10.740 µM/l | |
| 1 | 2 | 3 |
| 2 | 2 | 3 |
| 3 | 3 | 2 |
| 4 | 2 | 4 |
| 5 | 2 | 2 |
| 6 | 3 | 3 |
| 7 | 3 | 3 |
| 8 | 2 | 3 |
| 9 | 2 | 4 |
| 10 | 2 | 4 |
| 11 | 3 | 4 |
| 12 | 2 | 3 |
| 13 | 2 | 4 |
| 14 | 2 | 2 |
| 15 | 3 | 4 |
However, 15 randomly selected tissues from cultures with NAA were included in the experiment in order to make the results comparable with tissues developing on IBA media. All tissues were cultured as planned.
Seedlings developing on medium originally containing the growth regulator 4.920 µM/l IBA showed variable differences in development. Out of 15 seedlings, 8 died. The others developed slowly, the callus in the root was cream-coloured, browning in some places. On the medium containing 9.840 µM/l IBA, 10 seedlings survived and had longer shoots and creamy callus. IBA also induced the production of one trichome root at the lower concentration, and in the presence of 9.840 µM/l, 6 tissues grew a short, browning main root. Seedlings developing on medium with 5.370 µM/l NAA developed longer shoots, larger and more numerous leaves and a large number of trichome roots. Seedlings growing on a medium containing 10.740 µM/l NAA in terms of shoot length, size and number of leaves performed most favourably (Fig. 10, 11). They also developed viable main shoots and trichome roots. Calluses formed in the roots were compacted by the trichome roots, did not disintegrate and were orange-brown in colour.

Ulmus laevis seedlings developing on rooting WPM media. On medium supplemented with 4.920 µM/l IBA (A), callus was cream-coloured and the main root was browning. The tissues died at a rapid rate. On medium supplemented with 9.840 µM/l IBA (B), the seedlings produced a cream-coloured callus at the base. Their roots died most rapidly, resulting in the death of whole seedlings. On medium supplemented with 5.370 µM/l NAA (C), the callus tissue was orange in colour, and large numbers of root hairs developed from it. The seedlings had long, vigorous shoots with green leaves. On medium supplemented with 10.740 µM/l NAA (D), the seedlings achieved the required parameters. The callus in the roots was orange in colour with a large number of trichome roots growing out of it. In some cases, the beginnings of a primary root could be observed.

Pairwise comparisons using Wilcoxon rank sum test with continuity correction. The effect of the concentration of specific growth regulators on the growth of pedunculate elm seedlings was investigated: 5.370 µM/l NAA (Concentration_1), 10.740 µM/l NAA (Concentration_2), 4.920 µM/l IBA (Concentration_3) and 9.840 µM/l IBA (Concentration_4). Kruskal–Wallis chi-squared = 35.405, df = 3, p-value = 1e-07.
Within 14 days of culture under sterile conditions with access to natural light, tissues that were originally grown on the WPM medium with the IBA regulator died. Tissues derived from the WPM medium with 10.740 µM/l NAA (Fig. 12A) or 5.370 µM/l NAA (Fig. 12B) remained viable, so they were all cleaned of medium and superfluous elements and transferred to soil with perlite.

Ulmus laevis seedlings in passage from WPM medium with the addition of 10.740 µM/l NAA (A) or 5.370 µM/l NAA (B) to soil mixed with perlite at a ratio of 3:1 (C)
After 28 days, seedlings transferred to soil with perlite grown on medium with 5.370 µM/l NAA had shorter shoots and roots, and the leaves were fully developed. Seedlings grown on medium containing 10.740 µM/l NAA after transfer to soil with perlite reached an average size of 1.5–2 times larger than on medium supplemented with 5.370 µM/l. The large number of root hairs and their length showed the positive effect of the higher concentration on initial development. Leaves continued to be healthy and fully coloured (Fig. 12C).
An experiment was carried out on changes in the weight of callus obtained in step 3 (Fig. 13).
Comparison of a pair of Ulmus laevis callus grown on WPM medium supplemented with 4.646 µM/l KIN and 4.440 µM/l BA. The callus was divided into two equal parts by weight and one was transferred to the dark (A) and the other to the light (B) in the phytotron
Tissues developing under the light of the phytotron continued to be viable. The average weight after 21 days of culture was 0.163±0.031 g. Explants developing in the dark showed varied responses to the lack of light. Eleven of them increased their weight while continuing to take up nutrients from the medium, while the others stopped developing and started to lose weight. The average weight after 21 days was 0.129±0.027 g. The average weight of the initial callus was 0.121±0.027 g (Fig. 14).

Comparison of the mass of 45 calluses of U. laevis. Each callus divided into two parts came from a single zygotic embryo. One part of the callus was cultured in the light of the phytotron and another in the dark of the phytotron. The experiment lasted 21 days on WPM medium supplemented with 4.646 µM/l KIN and 4.440 µM/l BA. Paired t-test: t = 9.4479, df = 44, p-value = 3.737e-12
In this study, the in vitro micropropagation of Ulmus laevis embryos on different media was investigated and the effects of BAP, GA3, KIN and TDZ were assessed. The effect of light conditions on culture was also studied. From the result of the study, callus and seedlings obtained in vitro grew actively and survived without complications under artificial conditions. The transfer of seedlings into the soil did not cause dieback, and therefore, the embryo growth of elm was successful in the laboratory.
The protocol for obtaining tissues has shown that callus and seedling cultures can be used to maintain the genetic diversity of many biodiversity-enriching species. It further revealed that elm seed embryo can be successfully cultured. In the study of Fenning et al. (1993), proliferating U. procera shoot tip cultures was established on Driver and Kuniyuki Walnut medium (DKW). However, they failed to establish on Murashige and Skoog medium or Woody Plant medium. On DKW medium, shoots were produced per 3-week subculture period. In comparison to this method, Harvengt et al. (2004) used rooted microcuttings derived from green buds and cryopreserved winter buds of U. glabra, U. laevis and U. minor. Culture was conducted on 1/3 strength MS medium, which yielded rooted and unrooted micro-cuttings after 10–13 days. Modified MS medium was also used by Aoun et al. (2009), where U. americana buds initiated the callus growth within 6 weeks of culture. In the study of Välimäki et al. (2021), modified MS and WPM media were tested for U. laevis buds initiation. On MS medium, shoot development was observed after 1 to 2 weeks of culture. Although earlier studies on protocols for While most previous research on protocols for obtaining these elm tissues, as well as obtaining and rooting seedlings focuses on the flowers, however, this study has further established in vitro cultures of plant material different from buds for elm trees – embryos from immature seeds.
Teixeira da Silva et al. (2015) highlighted the importance of disinfection. Pre-disinfection time and detergent concentrations were also considered during the propagation of Anthurium andreanum. This improved the development of a protocol for the propagation of explants such as seeds, leaves or roots. For the stages concerning disinfection and culture medium selection for U. laevis, the tests were statistically significant. Multiple tests were carried out to improve disinfection. The result affirms that 8% H2O2 for the 15-minute disinfection protocol significantly affects the quality of the resulting explants due to the intrusion of the active agent into the seed. Välimäki et al. (2021) suggested correct and thorough disinfection of plant material when carried out, which significantly translated into the settlement of a culture medium suitable for the culture of both callus and seedlings.
The effect of light and darkness on the cultured tissues established how external conditions can influence physiological processes. The incubation process was carried out without light in the phytotron to make them autotrophic, and this was found to improve the growth of callus (Siddique and Islam 2018). Earlier Kintzios et al. (2002) reported that the induction of the callus of Lavandula vera in the darkness for 6 weeks in 25°C resulted in an improved callus growth. Under these conditions, somatic embryogenesis in lavender was reported to have significantly reduced.
The average weight of the tissues showed that there are differences between growing in light or dark. However, calluses were observed to form after 6 days in the dark condition in the presence of sucrose at 2% concentration. However, under light conditions, calluses already increase their weight after the first few days. Callus tissue was brittle regardless of light conditions and colour varied under all conditions. This corroborates Wahyuni et al. (2020): on MS medium supplemented with 2,4-D and BAP hormones and sucrose at different concentrations, differences were evident in the incubation of Justicia gendarussa on tissues in the light and dark conditions. The average weight of callus in the dark condition was 129 mg and 163 mg in the light condition. These values are more than 115.1 mg and 96.3 mg, respectively, reported by Suharanto et al. (2022) on Zea mays.
After obtaining viable shoots that demonstrated the ability to produce root hairs, an attempt was made to root them. The NAA and IBA regulators used for this are commonly used for elm seedling proliferation (Mezzetti et al. 1988; Corchete et al. 1997; Lee et al. 2021; Välimäki et al. 2021). According to a study on Melissa officinalis L., hormones from the auxin group do not have a significant effect on the rooting rate but on morphological characteristics of these plants (Sevik and Guney 2013). It follows that a similar effect occurs on U. laevis.
In the case of Ulmus laevis, numerous and healthy seedlings were also obtained. The rooting of seedlings in the present study was based on research by Välimäki et al. (2021) on elm species. The use of gradual adaptation of seedlings grown in vitro in a phytotron to the natural light conditions in the germinator resulted in faster adaptation to nutrient acquisition from photosynthesis. However, it was important to implement steps in this process and to reduce the concentration of nutrients in the culture medium. Fully developed U. laevis seedlings emerging from embryos obtained from immature seeds were transferred to the soil.
However, obtaining seedlings from buds can be similar to growing them from embryos. In this study, the seed expresses multiple seedlings which were still viable after separation.
However, in the case of buds (Välimäki et al. 2021), the seedlings did not show multiple shoot, which would have contributed to achieving more seedlings. In a research study carried out by Teixeira da Silva et al. (2017) on Dendrobium cuttings, it was very unfavourable to transplant from the culture medium directly into greenhouse conditions. This resulted in faster desiccation, wilting and death due to sudden environmental changes. In the case of Ulmus laevis, a large amount of hormone at the beginning of culture and later a reduction in its concentration had a positive effect on their adaptation to the new conditions and resulted in a clear stimulation of metabolic processes. Induction of rooting can, therefore, be carried out gradually to adapt them to the solid medium.
It was further discovered that despite genotypic differences, few of the tissues are susceptible to consistent regeneration conditions. Differences in structure and growth speed were evident between tissues. The refinement of the rooting method for U. laevis provides a basis for research into in vitro work leading to increased productivity in forest and urban ecosystems.
The development of micropropagation processes is a very important issue. Regeneration of adult Pinus pinaster trees is the subject of intensive research in the 21st century. In the study of De Diego et al. (2008), buds were cut and propagated on DCR medium with the growth regulator BA, and numerous healthy and well-rooted cuttings were obtained. It is, therefore, possible to study a large number of tissues without significant interference with the mother plant. However, the report of Kim and Hyun (2023) showed that bud removal in Platycodon grandiflorus affects plant development. Bud removal reduces GA3 production, which increases the root yield. It is possible that removing seeds and buds from trees also does not negatively affect the plant and even improves the production of substances inside the tree..
The callus and cuttings of white elm, therefore, make it possible to develop research in this area, as it has shown to significantly reduce the time to wait for breeding results. Pasternak and Steinmacher (2024) described that the use of organogenesis methods helps to optimise the seedling production process and the increase in the multiplication coefficient. This study showed with a high degree of certainty that the survival rate of callus depended on the chemical composition of the substrates on which they were located. However, it proved crucial to select growth regulators according to the type of tissues required for individual study. In turn, seedlings obtained under sterile conditions, according to the developed procedure, finally provide the basis on which to implement extensive pathogenicity studies.
The establishment of dual cultures involving callus or seedlings from a single genotype together with pathogen tissue can provide more information than other studies have done so far. Pathogenicity studies are time-consuming and difficult to carry out, but with a well-prepared material, problems such as infection can be avoided. Mohaddab et al. (2022) emphasise that dual cultures can be used to, among other things, produce secondary metabolites and increase physiological tasks as a response to stress.
Based on the result of the study, it can be concluded that the plant material should be taken straight from the plus tree with no signs of disease. There is every possibility that seedlings cultured in vitro and ex vitro after transfer to soil with perlite will be suitable for plantation establishment after 4 weeks. Given the rapidly progressing Dutch elm disease, protocols for obtaining a large number of seedlings in a short period of time may be essential when developing conservation methods. Also, the act of culturing callus in the laboratory should be focused more from seeds rather than from bud and cuttings. This established method of growing seedlings will increase the rate of seedling production for to meet the ever growing demand of silviculturist. As for the formation of callus on the culture medium, this is an improvement that can contribute to a lot of new research and analyses. Using the protocol from this paper to obtain calluses, they can be successfully cultured for further research in various branches of biotechnology and beyond.